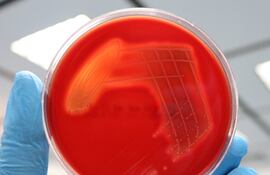
analisis

17 de enero de 2026

TOKIO. Las autoridades sanitarias de Japón están instando a la población a extremar las medidas higiénicas y de prevención por un fuerte aumento de las infecciones por una variante poco común de estreptococo, capaz de causar una enfermedad grave con una tasa de mortalidad del 30%.

SAN PABLO. Científicos brasileños descubrieron una bacteria en el suelo de la Amazonía que produce un compuesto con propiedades antitumorales similares a las de la quimioterapia, lo que podría ayudar a luchar contra el cáncer de mama y otras enfermedades, informaron este jueves los responsables del estudio.

GINEBRA. Un equipo de científicos de la Escuela Politécnica Federal de Lausana (EPFL) consiguió triplicar la capacidad para producir electricidad de la bacteria E.coli común mediante la modificación del microbio en diversos entornos, con resultados notables a partir de su presencia en aguas residuales.

La amenaza del cambio climático y el aumento de la población mundial son dos retos que requieren de una mejora del crecimiento de los cultivos. Un grupo de investigadores hizo una prueba preliminar para potenciar la fotosíntesis y la velocidad de los cultivos al elevar los niveles de CO2.